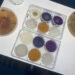
Produire des biocarburants de 2ème génération avec des champignons

Etoiles, planètes, galaxies… Toute la matière visible ne constitue que 5% de l’Univers. Le reste? On n’en sait rien : c’est ce que les scientifiques appellent « la matière sombre et l’énergie sombre ». La satellite Euclid doit en percer les mystères.
Pour les scientifiques, découvrir la nature de ces deux entités invisibles – « la matière sombre » et « énergie sombre » –, c’est crucial, comme l’explique Martin Kunz, professeur d’astrophysique théorique à l’Université de Genève, et coordinateur des efforts pour Euclid en Suisse: « Nous espérons que cela va mener à une révolution de nos connaissances comparable à ce qui s’est passé au début du XXe siècle avec la découverte de la physique quantique et de la relativité générale. »
Pour percer ce mystère, une fusée SpaceX doit lancer ce 1er juillet le télescope spatial européen Euclid. Sa tâche : scruter un tiers de l’entier du ciel en observant un milliard de galaxies, pour traquer la matière et l’énergie sombres. Comment ? A l’aide de la méthode de la « lentille gravitationnelle »
Dans le vide, la lumière des galaxies atteint la Terre en principe en ligne droite. Mais si une grande quantité de masse se trouve sur son trajet – comme de la matière sombre – la lumière est déviée par la force de gravitation exercée par cette masse. De la Terre, on voit alors de ces galaxies des images très distordues, allongées, en forme de croissants très plats. Pour les scientifiques, c’est cet effet de loupe qui révèle la présence de matière sombre.
Euclid doit en dessiner la distribution et la forme dans une carte en trois dimensions précise comme jamais – en rouge dans cette simulation.
Budget de 1,4 milliard d’euros
Avec un budget d’ 1,4 milliard d’euros, Euclid est l’une des missions les plus importante de l’Europe spatiale, réunissant 3000 scientifiques de 21 pays. Martin Kunz: « La contribution de la Suisse est très importante. On a contribué à un élément d’un des détecteurs qui est essentiel, sans lequel le télescope ne marcherait pas, mais on est aussi très fortement impliqué dans le traitement et l’analyse des données. »
Des données qui permettront aussi de reconstruire l’histoire de l’Univers jusqu’à 10 milliards d’années. Et donc, peut-être, de faire la lumière sur son côté sombre.